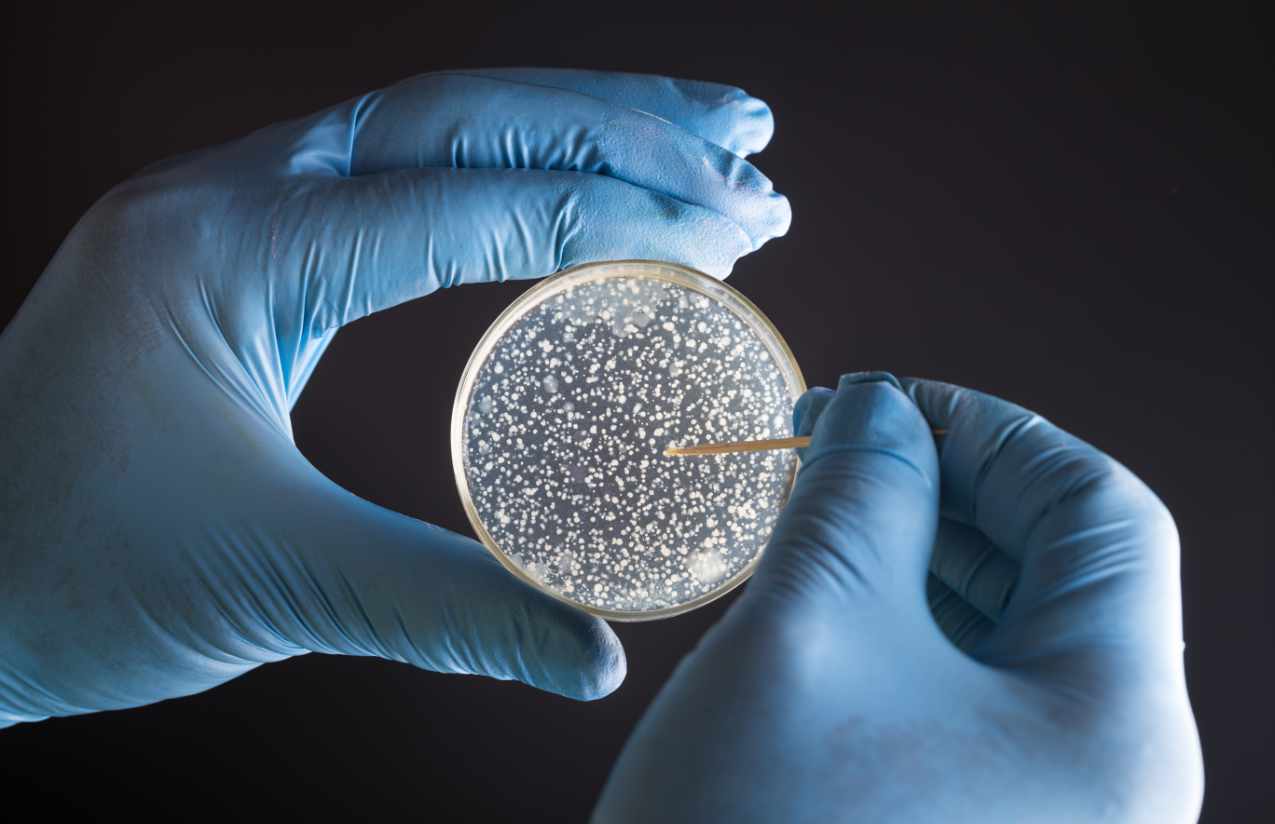

Trinken Sie gesundes vitales Wasser?
Bei uns im Wasser-Blog finden und lernen Sie alles rund um das Thema Trinkwasser und Trinkwasseroptimierung...

Wissenswertes
Was sagen Stiftung Warentest & ÖKO-Test zu unserem Wasser?
Wie gut ist das deutsche Trinkwasser? Diese Frage stellen sich immer mehr Verbraucher und greifen...

Wissenswertes
Eine Frage der Definition: sauberes, gutes, bestes Trinkwasser
Wasser ist für das Leben auf der Erde sehr entscheidend. Trinkwasser gilt als Flüssigkeitsspender...

Wissenswertes
Kein Trinkwasser – was bedeutet das?
Fast allen Menschen dürfte der Warnhinweis „kein Trinkwasser“ an Brunnen oder öffentlichen Hähnen...

Wissenswertes
Kann man Trinkwasser haltbar machen?
Allen Beteuerungen der Wasserwerke zum Trotz über die theoretisch unbegrenzte Haltbarkeit von Tri...

Wissenswertes
Wasserleitungen: Das Material bestimmt den Reinheitsgrad unseres Trinkwassers
Die Art und Beschaffenheit der eigenen Wasserleitungen entscheidet über die Wasserqualität mit. A...

Wissenswertes
Der Nestle-Trinkwasser Skandal
Nestle gehört zu den berühmtesten und einflussreichsten Global Playern überhaupt. Ein weltweiter ...
Wissenswertes
Was versteht man unter koloniebildenden Einheiten oder der Gesamtkeimzahl?
Die Gesamtkeimzahl ist eine Maßeinheit zur Ermittlung der mikrobiologischen Belastung des Trinkwa...

Wissenswertes
Wie viel Trinkwasser kann bereits durch einen Tropfen Öl ungenießbar werden?
Öl und Wasser vertragen sich bekanntlich nicht. Bereits dieser Antagonismus bestimmt die Definiti...

Wissenswertes
Was ist Osmosewasser?
Umkehrosmose-Filteranlagen basieren auf einer Trennwand (einer semipermeablen Membran), welche nu...

Häufige und beliebte Suchbegriffe für: